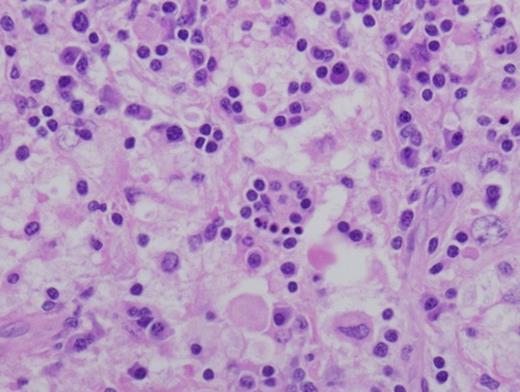
Left parotidectomy specimen showing histiocytes with marked emperiopolesis of leukocytes. Hematoxylin and Eosin stain of Paraffin embedded surgically removed parotid mass tissue viewed at 600x.
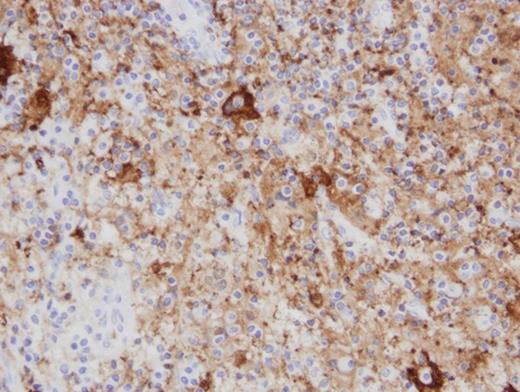
An Immunohistochemistry stain shows s100 protein deposition within the histiocytes. S100 immunohistochemistry stain of Paraffin embedded surgically removed parotid mass tissue viewed at 400x.

-
PDF
- Split View
-
Views
-
Cite
Cite
JK Byrd, LJ Overton, TA Goldin, EJ Lentsch, Rosai Dorfman Disease presenting as unilateral chronic parotitis, Journal of Surgical Case Reports, Volume 2012, Issue 6, June 2012, Page 7, https://doi.org/10.1093/jscr/2012.6.7
Close - Share Icon Share
Abstract
We report a 48-year-old man who presents with a 20-month history of left parotid enlargement despite treatment with antibiotics and steroids. He presented with a non-painful palpable mass in his left parotid without facial weakness or otologic symptoms. Fine needle aspiration was inconclusive, and an attempted excisional biopsy was aborted due to involvement of the facial nerve and suspicion of lymphoma. Subsequently, he underwent a total parotidectomy with facial nerve preservation. The specimen yielded results that were consistent with Rosai-Dorfman disease. Of note in our patient is the lack of cervical lymphadenopathy, which classically presents with this condition. Head and neck extranodal involvement, while not unusual for Rosai-Dorfman, is rarely seen in the parotid. Previous reports of this disease found in the parotid indicate an underlying autoimmune process, which was not found in this patient.
INTRODUCTION
Rosai-Dorfman Disease, or Sinus Histiocytosis with Massive Lymphadenopathy (SHML), is a rare benign, self-limited disease with a predilection for head and neck involvement. It most commonly presents with bilateral cervical lymphadenopathy (1), but SHML may also present without clinically evident nodal involvement, making diagnosis difficult. The clinical course is characterized by exacerbations and remissions over the long-term (1). It may also be mistaken for other benign or malignant entities; therefore histologic analysis remains the mainstay of diagnosis.
Our report defines a rare case in which there is presentation of an isolated unilateral parotid gland involvement. Uniquely, although extranodal sites of SHML are typically found in the head and neck, they rarely involve the salivary glands (1).
CASE REPORT
A 48-year-old African American male presented to an outside institution in September 2008 with a painless, gradually enlarging palpable left parotid mass without facial nerve involvement. He is a nonsmoker, and his medical history was not notable for any chronic medical conditions or previous surgeries. Computerized tomography and magnetic resonance imaging revealed a well-circumscribed 2.9 x 3.6 x 2.4 cm mass within the superficial lobe of the diffusely enlarged left parotid gland. The mass was abutting but not extending into the deep lobe, being most consistent with pleomorphic adenoma with shotty bilateral level 1 and 2 lymph nodes of subclinical size showing no evidence of cervical lymhadenpathy. Laboratory investigation was negative for HIV, and white blood cell count was normal with a mildly elevated erythrocyte sedimentation rate.

Fine needle aspiration biopsy revealed lymphocytes, oncocytic cells and proteinaceous debris. Initial attempt at excision in November 2008 was aborted due a dense, firm mass abutting the frontal branch of the facial nerve, and extending under the zygomatic arch into the infratemporal fossa. A small wedge biopsy was taken as an intraoperative frozen section, which was negative for malignant cells. The pathologist noted only a lymphoplasmacytic inflammatory infiltrate and dense fibrosis with foamy macrophages, occasional multinucleated giant cells, and occasional lymphoid follicles. This was thought to represent Mikulicz Syndrome, and preauricular lymph nodes removed at the time of biopsy were consistent with benign fibrotic nodes.

Postoperative prednisone taper treatment successfully decreased the size of the mass and was administered periodically as observation required. A repeat CT scan in July 2009 revealed a diffusely enlarged left parotid gland with complete resolution of the discrete mass (Fig.1–2). He was conservatively managed with periodic steroids until April 2010, when he complained of pain in the region and a feeling of gradual increase in size. A left parotidectomy was performed in May 2010, with removal of both the superficial and deep lobes of the parotid gland along with identification and preservation of the facial nerve.
Left parotidectomy specimen showing histiocytes with marked emperiopolesis of leukocytes. Hematoxylin and Eosin stain of Paraffin embedded surgically removed parotid mass tissue viewed at 600x.
The parotidectomy specimen consisted of a multinodular mass measuring 3 x 2 x 1 cm, and weighing 7.4 grams arising within an enlarged parotid gland. The nodules showed a well-circumscribed, homogeneous, yellow-tan cut surface. The remainder of the parotid gland was grossly unremarkable.
An Immunohistochemistry stain shows s100 protein deposition within the histiocytes. S100 immunohistochemistry stain of Paraffin embedded surgically removed parotid mass tissue viewed at 400x.
Histologic examination on hematoxylin and eosin stained paraffin-embedded tissue revealed replacement of the parotid gland with sheets of large histiocytic cells containing abundant clear to eosinophilic cytoplasm and large vesicular nuclei. Many histiocytes showed emperipolesis, with engulfed and partially digested plasma cells, lymphocytes and neutrophils (Fig.3). Immunohistochemistry stains for s100 protein were strongly positive in the histiocytes (Fig.4) and stains for CD1a were diffusely negative. Interestingly, in-situ hybridization for kappa and lambda proteins showed a marked kappa-predominance within the plasma cells with Russell Bodies, though definitive light-chain restriction was not identified.
DISCUSSION
Sinus histiocytosis with massive lymphadenopathy (SHML) was first described by Rosai and Dorfman in 1969 as a disease characterized by nodal histiocytic infiltration (2). It is a benign condition with unknown etiology that most commonly presents with painless bilateral cervical lymphadenopathy (2). 43% of patients exhibit extranodal involvement, 75% of which being found in the head and neck region; most commonly involving the skin, paranasal sinuses, nasal cavity, subcutaneous tissue, orbit, eyelids and bone (1).
Histiocytes in SHML characteristically exhibit emperipolesis: a process by which intact cells are found in the cytoplasm of the histiocytes. Histopathological findings reveal positive S100 with negative CD1a in this patient, which are relevant diagnostic criteria for SHML as well(3).
Over 95% of patients present with a several month history of bilateral cervical lymphadenopathy (4). Previous reports of SHML with extranodal manifestation in the parotid gland refer to patients with an established immunologic disease (5), and it has been noted that patients with extranodal involvement of the head and neck tend to have higher rates of immunologic abnormalities (6). The disease is presently of unknown etiology; however, many causes have been proposed without substantiation including immunodeficiency, autoimmune disease, viral illness, and neoplastic processes (7).
A characteristic pathological feature of SHML is the noted infiltration of histiocytic cells in a background of mixed inflammatory cells (1,8). The case we present involves diffuse parotid gland involvement with extensive replacement of parotid gland parynchyma with histiocytic cells in a background of lymphocytes and plasma cells containing Russell Bodies. Overall, this represents a rare site of SHML involvement in an immunocompetent individual, and consideration should be given to this diagnosis in cases of diffuse parotid enlargement. In the majority of cases, SHML has a benign course. Therefore treatment is not usually necessary with surgery being generally limited to biopsy.